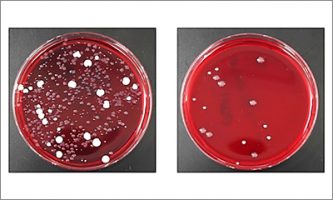

News
Category
-

Elucidating a key mechanism underlying cancer invasion/metastasis: Discovery of a unique hydroxylase “PLOD2” essential to the functional activation of integrin on cancer cells.
Research results
-
Discovery of the protective effect of a plant-based compound against periodontitis: Report by a graduate student and other researchers at Niigata University and Kobayashi Pharmaceutical Co., Ltd.
Research results
-

2019 Autumn Semester Closing Ceremony for International Students
Topics
-

Development of a diagnostic and severity marker for Stevens-Johnson syndrome and toxic epidermal necrolysis: Serum RIP3 measurement shown to be a useful testing method
Research results
-

Prof. USHIKI Tatsuo has become the new President
Topics
-

Chinese New Year Party at Niigata University
Events
-

Non-communicable diseases and nursing care need examined through the medical big data of Sanjo City: Regular exercise can reduce diabetic patient risk of having to need nursing care to the same as that of non-diabetics
Research results
-

2020 New Year's Party
Events
